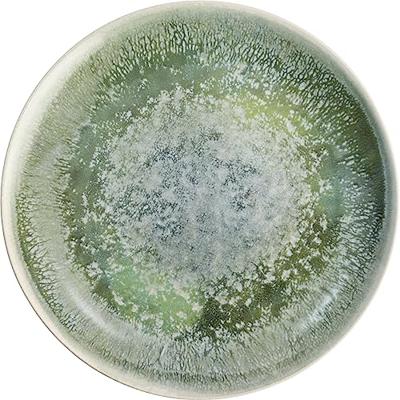
Lite-Body - Serviesset Hermes - 6 personen - 24 delig - Groen reliëf

24 delige serviesset - 6 personen - Lagos - wit met bruine spikkel - Portugees stoneware
Hoogwaardig Portugees Aardenwerk - Exclusief, Uniek, Eerlijk GemaaktHoogwaardige horeca kwaliteitOntdek onze exclusieve Lagos Serviesset: een uniek samengestelde serviesset voor 6 personen, alleen verkrijgbaar bij Kade 171. Deze unieke set is het resultaat is van ambacht volgens de Portugese traditie. Gemaakt met de grootste aandacht voor detail.Een unieke mix van traditie, stijl en horeca kwaliteitWat deze serviesset voor 6 personen nog opmerkelijker maakt, is haar hogewaardige horecakwaliteit. Het is ontworpen om de eisen van zelfs de meest veeleisende horeca-omgevingen te weerstaan. Dit betekent dat je niet alleen kunt genieten van zijn prachtige esthetiek thuis, maar ook kunt vertrouwen op zijn duurzaamheid en kwaliteit van deze set. Duurzame kwaliteitDit hoogwaardige Portugees aardenwerk is met de hand vervaardigd met behulp van eeuwenoude technieken die van generatie op generatie zijn doorgegeven. Het resultaat is een servies van ongeëvenaarde kwaliteit en duurzaamheid. Elk bord,…
169,-
119,-